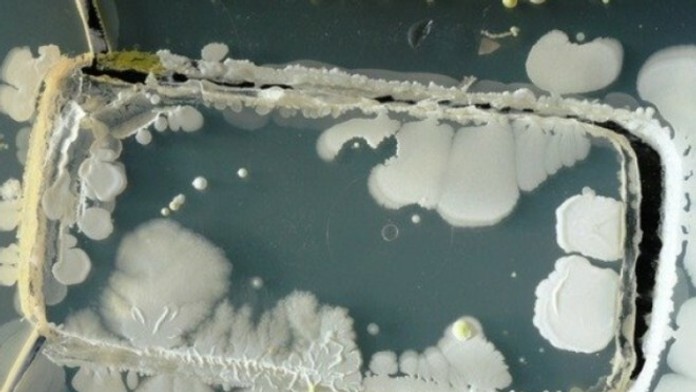
Bakterie na mobile3.jpg
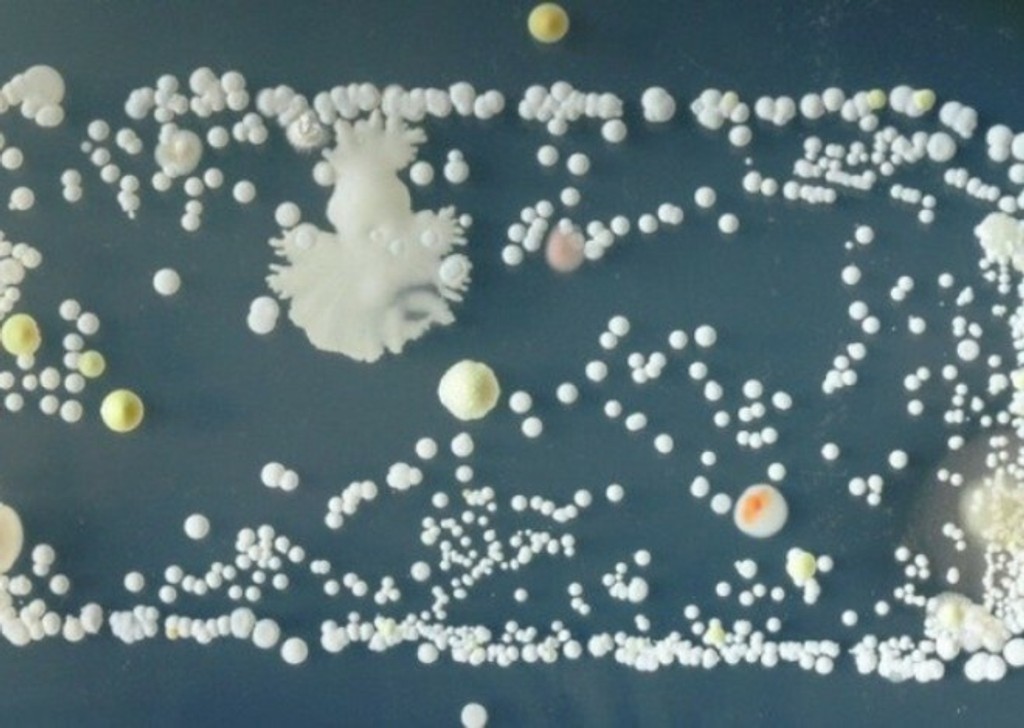
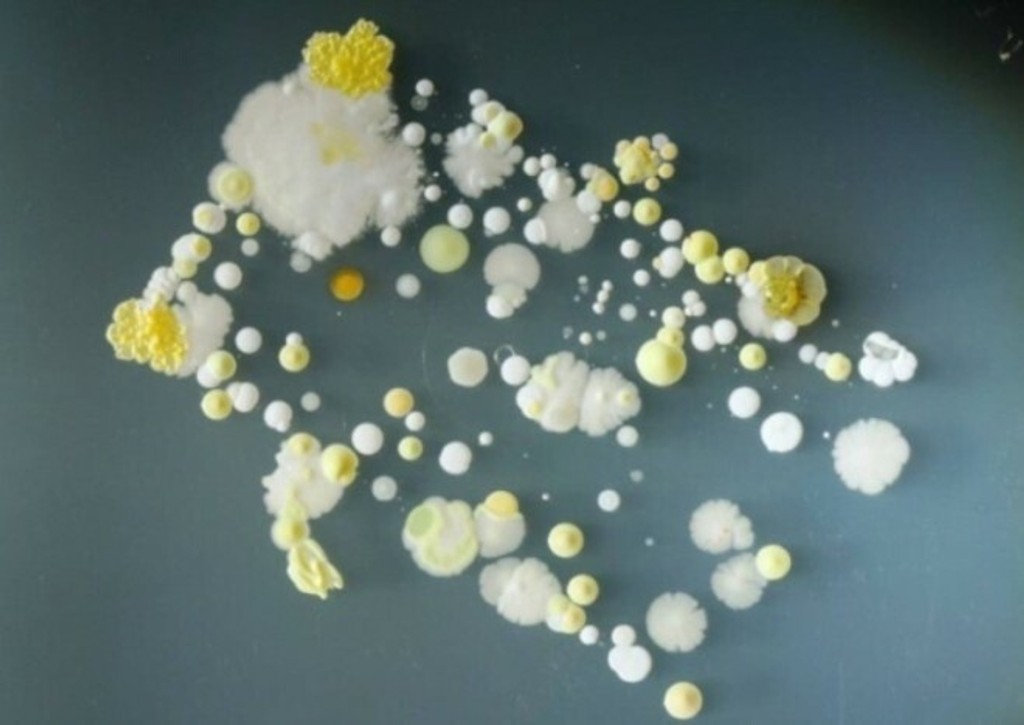
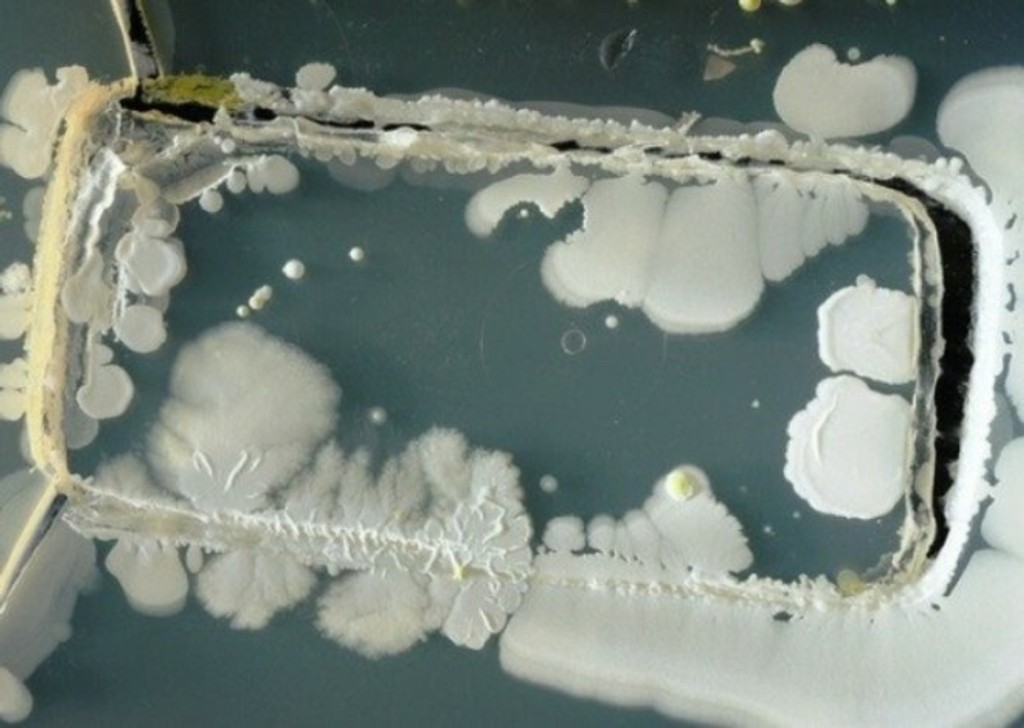
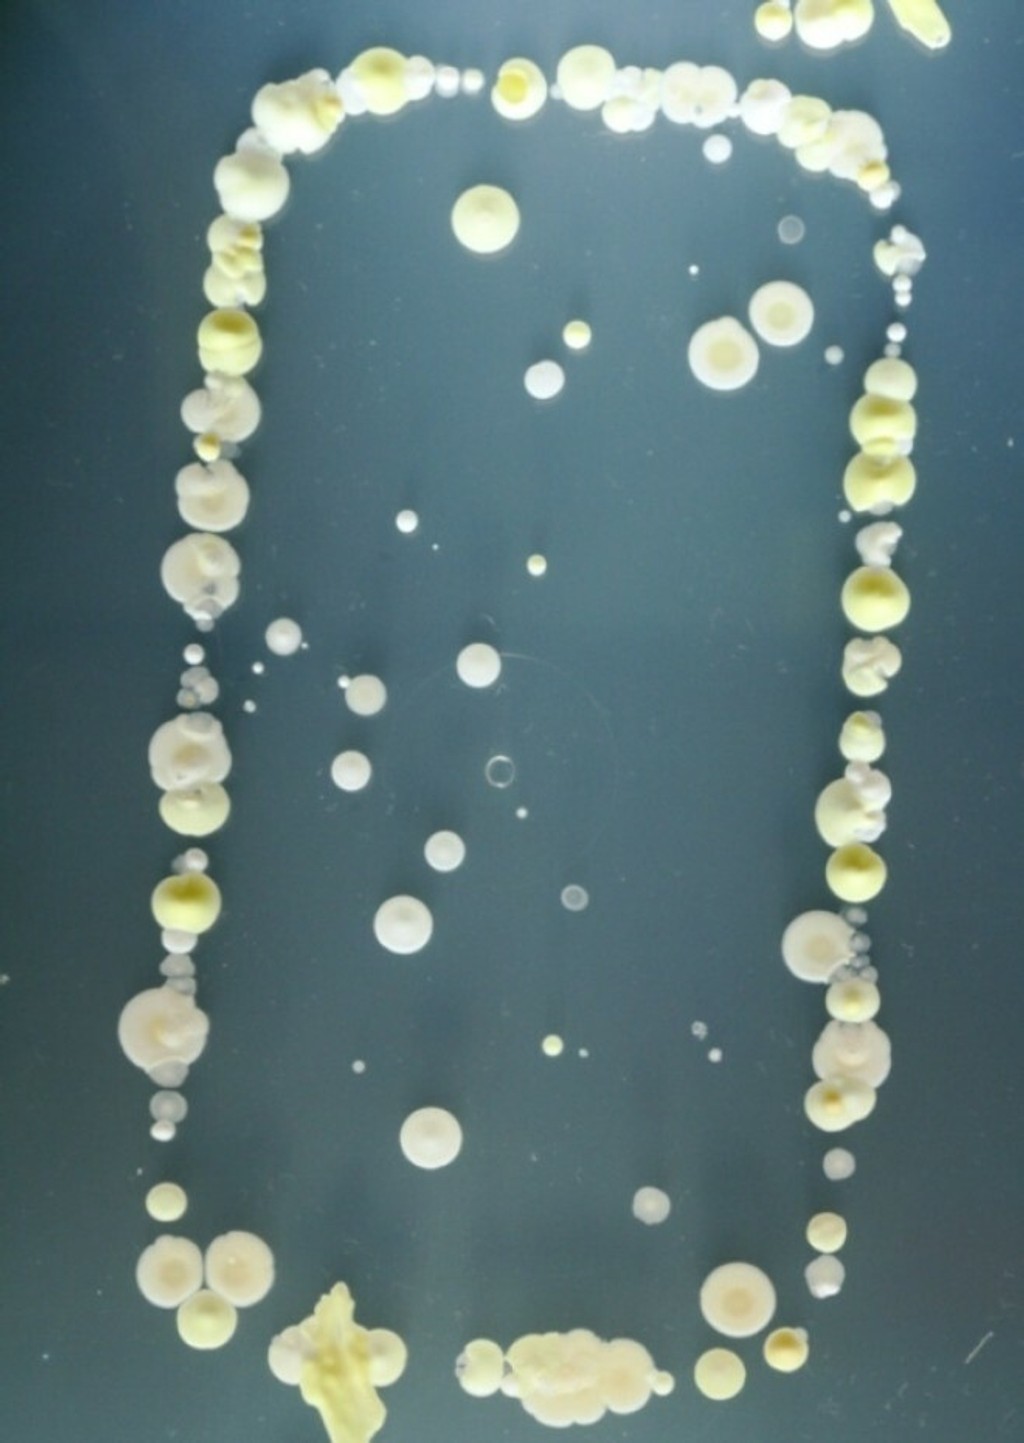

Takto vyzerajú kolónie baktérií na vašom mobile. Ako sa ich zbavíte?
Na mobile nájdete až 144-tisíc kolónií baktérií. Na splachovadle WC je ich len 8-tisíc.
Myslíte si, že len verejné záchody sú prešpikované baktériami? Tak sa lepšie pozrite na váš mobilný telefón. Na ňom objavíte 18-krát viac baktérií ako na splachovači WC. Študenti z britskej univerzity v Surrey zverejnili otrasné fotky ako sú naše mobilné telefóny doslova posiate baktériami.
Väčšina z nich síce nie sú nebezpečné, no nájdete medzi nimi aj takých "chlapíkov" akým je zlatý stafylokok, ktorý môže spôsobiť vážne zdravotné problémy - od infekcií až po otravu krvi. Stále však platí, že väčšina zo 144-tisíc baktérií, ktoré sa v priemere na mobiloch nachádzajú, sú neškodné, píše tn.cz.
Študenti z britskej univerzity vložili svoje telefóny do Petriho mysiek. Po troch dňoch sa ukázali výsledky - a tie boli naozaj nechutné. Študenti "zamorené" telefóny odfotili a snímky zverejnili.
Kým mobil ma na sebe okolo 144-tisíc kolónií baktérií, splachovadlo WC 8-tisíc, kľučky na dverách 7-tisíc, tlačidlá na bankomate 150 a bankovka 120 kolónií.
A čo robiť s takýmto kontaminovaným mobilom? Profesor univerzity v Surrey odporúča dezinfikovať mobil každý týždeň. Jednoducho ho poutierate handričkou na okuliare namočnou v technickom liehu.

Sledujte Televízne noviny vo full HD a bez reklám na Voyo































